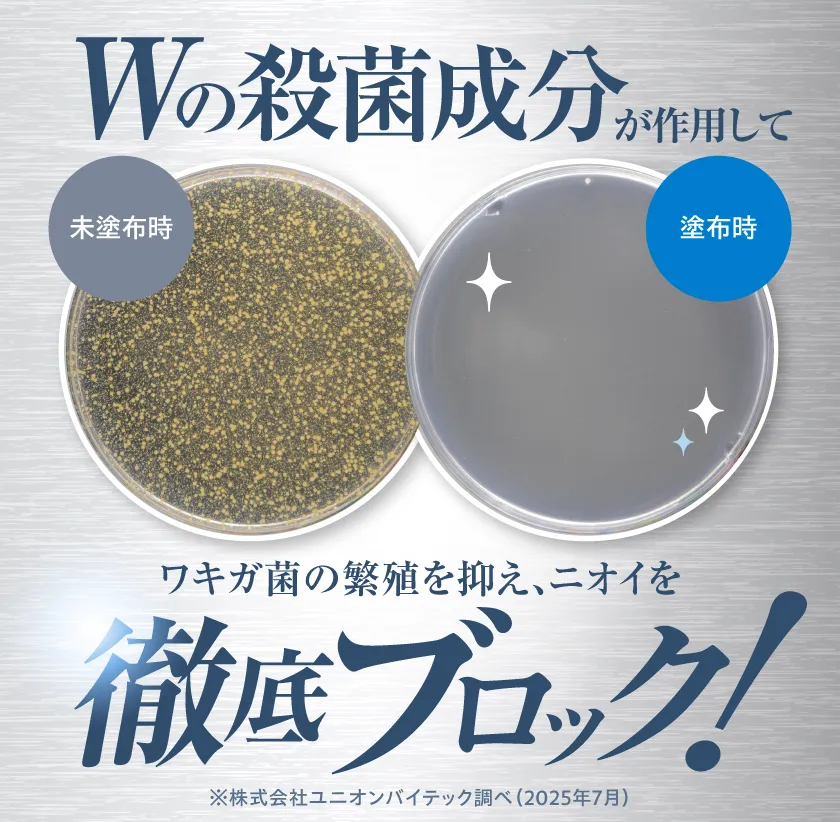
プルーストクリーム2.0

【新品】プルーストクリーム30g✖︎2本 プルーストクリーム PROUST CREAM 30g 2本セット 医薬部外品|Yahoo
(3055件)
Pontaパス特典
サンキュー配送
6000円(税込)
60ポイント(1%)
Pontaパス会員ならさらに+1%ポイント還元!
送料
(
)
3042
配送情報
お届け予定日:2026.04.22 7:19までにお届け
※一部地域・離島につきましては、表示のお届け予定日期間内にお届けできない場合があります。
ロットナンバー
79853123450
お買い物の前にチェック!

Pontaパス会員なら
ポイント+1%
ポイント+1%
商品説明



ご閲覧ありがとうございます。PROUST CREAMプルーストクリーム 30g ×2本新品未使用品です。#プルーストクリーム#制汗、デオドラント#コスメ、美容#ボディケア
| カテゴリー: | コスメ・美容>>>ボディケア>>>ハンドケア・ハンドクリーム |
|---|---|
| 商品の状態: | 新品、未使用","新品で購入し、一度も使用していない |
| 配送料の負担: | 送料込み(出品者負担) |
| 配送の方法: | 佐川急便/日本郵便 |
| 発送元の地域: | 長野県 |
| 発送までの日数: | 1~2日で発送 |
レビュー
商品の評価:




 4.2点(3055件)
4.2点(3055件)
- ボーナスショップ
- 臭いは抑えられないようです。効果ないかも…
- ばに23
- ずっとこれを使っています。お安く買えてありがたいです。
- とむぼーいず
- 耳洗潔オリジナルを以前使用していて、 検索した所 姫路流通センターさんの この商品がヒット、 これから夏が来るし、 スッキリ爽快感をもっと味わいたい!と、 プレゼント分も合わせて3つ購入。 3つセットだと超お買い得で送料込で 値段は本当は誰にも教えたくないくらい(笑)。 商品は、思った通り、スーッとして、ジ〜ンと後から来て、 もう本当クセになります。ヤミツキ〜! 刺激を求めている人に絶対おススメです。
- ごろう6993
- 体臭予防で前から飲んでます♪♪ 違う通販ショップより安い!!なので購入しちゃいました♪♪ 届くのが楽しみです\(^o^)/
- usakonopage
- レビューほどの効果を実感できませんでした。 体質によるかも思います。 私には合わなかったみたい。 残念です。
すべて見る
お店の情報
7,367
連絡・応対
4.3
配送スピード
4.3
梱包
4.3